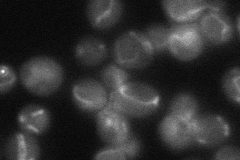
YPR004C

View description
Protein with similarity to mammalian electron transfer flavoprotein complex subunit ETF-alpha; interacts with frataxin, Yfh1p; null mutant displays elevated frequency of mitochondrial genome loss
Localization:
Intensity:
Fold change:
Significance:
-
C’ GFP library in SD

mitochondria107.59 -
N' NOP1pr-GFP in SD

mitochondria104.339 -
N' TEF2pr-mCherry in SD

missing0 -
N' NATIVEpr-GFP in SD
mitochondria42.0525 -
N' TEF2pr-VC and Cyto-VN in SD

#N/A0 -
C’ GFP library in SD+DTT

mitochondria102.80.95No -
C’ GFP library in SD+H2O2

mitochondria95.961Yes -
C’ GFP library in Starvation Media

mitochondria164.671.53Yes -
C’ GFP library on the background of Pup2-DaMP

mitochondria -
C’ GFP library on the background of CCT mutant

mitochondria120.1221.11637No
